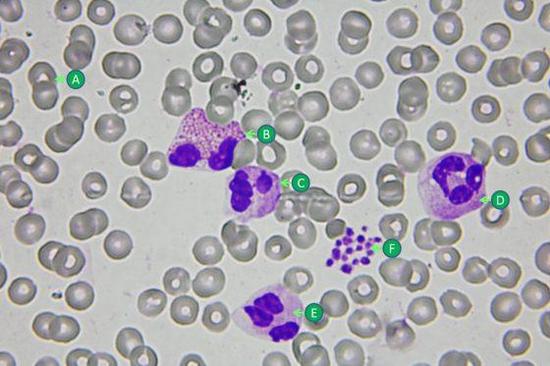

星期一,听起来是什么颜色?
先别急着回答蓝色,对某些人来说,这个答案可不是受到情绪经验的影响,而是...

人体中细胞的工作过程有多奥妙?日本近期动画《工作细胞》就用幽默可爱的风格为我们介绍。血小板是个默默工作的小萝莉...
🔖
癌症,
细菌,
细胞,
科学家,
环境,
微生物,
血小板,
抗癌,
生物学,
癌细胞,
萝莉,
疾病,
白血球,
修复,

吸吸更健康(Clyde Putnam Jr. photo/Thomas Robinson)
仅仅...

1968年五月时,一名叫做瑞德尔(Wilbur Riddle)的挖井人沿着美国25号公路迈进,他的目标是要到肯...
红血球其实像颗贝果面包,至于白血球咩,比较像是颗煎坏的荷包蛋……
《工作细胞》里的角色多是可爱的红血球小姐、帅气的...
🔖
dna,
遗传,
细菌,
细胞,
寄生虫,
科学家,
微生物,
血小板,
沉默的羔羊,
病毒,
瘤,
肿瘤,
食物,
萝莉,
白血球,